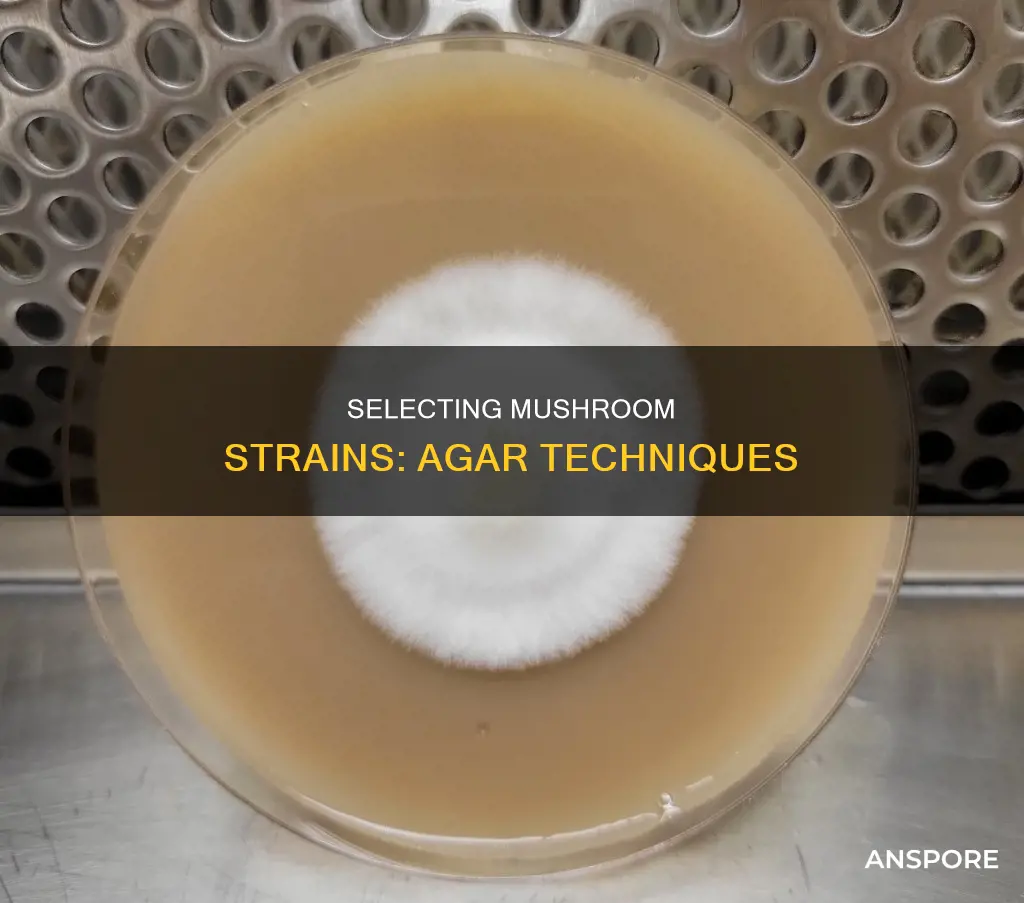
how select mushroom strain from agar

Agar is a gelatinous substance derived from red seaweed that is used in mushroom cultivation. It is used to germinate spores and culture mycelium, providing a nutrient-rich medium for the mushrooms to grow. The clear medium allows cultivators to observe the growth and health of the mycelium, isolate pure cultures, and identify any contamination. To select a mushroom strain from agar, one must first introduce spores or mycelium onto the agar plate. The agar plate should be stored in a clean, dark, temperature-controlled environment, typically around 70-75°F (21-24°C). Mycelium growth can take anywhere from several days to a few weeks, depending on the strain. Once the mycelium has grown, it can be isolated and transferred to a new agar plate to grow separately. This process can be repeated until the desired mushroom strain is achieved.
Explore related products
$14.95
What You'll Learn

Cloning a mushroom strain
To clone a mushroom strain, you will need to start with a mushroom mycelium that is healthy and free from contamination. You can obtain a mycelium from a store-bought or wild mushroom. Once you have selected your mushroom mycelium, you will need to clean the surface with alcohol to sterilize it. Using a sterile scalpel or razor blade, carefully remove a small piece of tissue from either your petri dish or from the stem or cap of the mushroom. The tissue should be no larger than a grain of rice.
The next step is to place the small piece of mycelium on an agar plate. Agar is a gelatinous substance derived from algae that is commonly used in microbiology to grow microorganisms. Seal the agar plate using parafilm or masking tape to prevent contaminants from entering. Label the plate with the date and mushroom strain, and store it in a dark, temperature-controlled environment (around 70-75°F or 21-24°C).
Monitor the plate for mycelium growth, which can take anywhere from several days to a few weeks, depending on the strain. As the mycelium grows, keep an eye out for any signs of contamination, such as off-colour growth or unpleasant odours. If the agar plate is fully colonized with mycelium, you can store it in the refrigerator for several months, ensuring a continuous supply of mycelium for future projects.
You can continue to "clone" your desired strain by taking small sections of the mycelium and passaging it onto new agar petri dishes to let it grow out. This is the fragmentation part of asexual reproduction. You can also let the mycelium develop into fruits and collect the spores in a spore print to preserve the genetics in a more stable spore form.
Mushroom Magic: Best Types for Burgers
You may want to see also

Using pre-poured agar plates
Pre-poured agar plates are typically shipped fresh to ensure their effectiveness. They are prepared with a blend of light malt extract and agar, a gelatinous substance derived from algae that provides a nutrient-rich and sterile medium for fungi to grow. The plates are 90 x 15 mm in dimension and are carefully sterilised to prevent any unwanted bacterial growth.
To use pre-poured agar plates, it is recommended to store them at a temperature of 70-75°F (21-24°C) in a clean, dark environment before use. Mycelium growth typically occurs within 3–10 days. It is important to regularly monitor the plates for any signs of contamination, such as green, black, or bacterial growth. If contamination is detected, the plate should be discarded. However, if the contamination is not severe, it is possible to avoid the affected region when cutting the mycelium for further use.
Inoculating the agar plates is a crucial step in the process. This involves introducing spores, liquid culture, or tissue onto the agar surface using a sterile scalpel or inoculation loop. The plate is then sealed with parafilm, labelled, and incubated at a similar temperature range of 65-75°F in a dark area to encourage mycelium growth. Daily monitoring is essential to catch any signs of contamination early and ensure the successful cultivation of the desired mushroom strain.
Pre-poured agar plates offer a simple and efficient way to work with mushroom cultures, isolate specific genetic traits, and conduct selective breeding experiments. They are a valuable tool for mycologists and enthusiasts, providing consistent and reliable results in mushroom strain selection and cultivation.
Mushroom Taste: How Substrates Make a Difference
You may want to see also

Inoculating an agar plate
Agar plates are a foundational tool in mycology and mushroom cultivation, providing a nutrient-rich, sterile medium for fungi to grow. They are used to isolate and select specific strains of mushrooms for further cultivation.
Prepare the agar plates: If not using pre-poured plates, mix and pour your agar in a sterile environment, ensuring it sets before inoculation. Store agar plates at 70-75°F (21-24°C) in a clean, dark environment.
Inoculate the agar: In a sterile environment, use a scalpel or inoculation loop to introduce your sample (spores, tissue, or LC) onto the agar surface. Be careful not to oversaturate the plate; a light misting is sufficient to begin the culture.
Seal and incubate: Seal the plate with parafilm and label it with the date, strain information, and any other relevant information. Incubate the plate at the appropriate temperature and humidity conditions for the particular mushroom species. For most species, agar plates can be incubated at room temperature.
Monitor growth: Check the plate regularly for mycelium growth and any signs of contamination. Mycelium growth typically appears within 3–10 days, but some species may take longer. Healthy mycelium is typically white and fluffy or thread-like, spreading evenly across the agar surface. It should not have any discolorations or unusual textures.
Work sterile: Always use sterilized tools and a clean workspace to prevent contamination. Sterilize your workspace with an alcohol burner and work within a still air box or in front of a laminar flow hood for best results. Sterilize tools such as scalpels, inoculation loops, and tweezers with a flame or alcohol and allow them to cool before use.
By following these steps, you can successfully inoculate an agar plate and select specific strains of mushrooms for further cultivation.
Mushroom Cultivation: Pounds of Substrate Needed
You may want to see also
Explore related products
$14.95

Selecting the best mycelium
Prepare the Agar Plates
If using pre-poured plates is not an option, it is important to mix and pour agar in a sterile environment, ensuring it sets before inoculation. The agar should be poured at a temperature of about 40–50°C to avoid clotting or condensation issues.
Inoculate the Agar
In a sterile environment, use a scalpel or inoculation loop to introduce a small piece of mycelium onto the agar surface. The mycelium should be taken from a healthy and uncontaminated source, such as another agar plate or a mushroom fruiting body. The tissue sample should be no larger than a grain of rice.
Seal and Incubate
Seal the plate with parafilm or masking tape to prevent contamination. Label the plate with the date and mushroom strain. Store it in a dark, temperature-controlled environment at around 65-75°F (21-24°C).
Monitor Growth
Mycelium growth can take anywhere from several days to a few weeks. Regularly check the plate for signs of contamination, such as off-colour growth or unpleasant odours. If contamination occurs, you may be able to extract a clean sample of mycelium and transfer it to a new plate.
Select the Strongest Mycelium
Once the mycelium has grown, you can select the strongest and healthiest specimen. Look for Rhizomorph Mycelium, which has a wiry-type structure and a larger potential to grow into healthy mushrooms. You can cut out the desired mycelium and place it in a new dish with agar to promote further growth.
Repeat the Process
To ensure purity and stability, the process of isolating and transferring mycelium to new agar plates can be repeated multiple times. This helps to select the best mycelium and maintain the vitality of the strain.
Mushrooms: A Toxic Foray
You may want to see also

Storing the agar plate
Storing agar plates is a fundamental skill in mushroom cultivation. Agar plates provide a controlled, sterile environment for growing and observing mushroom mycelium, allowing cultivators to isolate and propagate healthy strains.
Storing Agar Plates Before Inoculation
Before inoculation, agar plates should be sealed with Parafilm or plastic wrap to keep them sterile. They should be stored upside down (lid down) to prevent condensation from dripping onto the agar surface. It is recommended to let the agar sit at room temperature for a few days before inoculation to ensure there is no unwanted growth.
Storing Agar Plates After Inoculation
After inoculation, agar plates should be stored in a temperature-controlled space with the temperature maintained between 75-80°F (24-27°C). It is important to regularly monitor the plates for signs of mycelial growth and contamination. If contamination occurs, the affected plate should be removed to prevent the spread to other plates. Once the agar is fully colonized, the mycelium can be transferred to a new plate to continue growth.
Long-Term Storage of Agar Plates
For long-term storage, it is recommended to use culture slants instead of agar plates. Culture slants are test tubes filled with agar that are cooled at an angle to provide more surface area for the mycelium to grow. These tubes are easier to seal and take up less space in the refrigerator, where they can be stored for up to three years.
Mushrooms in Your Yard: Are They Toxic?
You may want to see also
Frequently asked questions
First, select mushrooms that exhibit the traits you wish to cultivate, such as rapid growth, large fruiting bodies, or high potency. Next, clean the surface with alcohol to sterilize it. Using a sterile scalpel or razor blade, carefully remove a small piece of tissue from the mushroom. The tissue should be no larger than a grain of rice. Place the agar plate in a clean, dark environment at a temperature of 70-75°F (21-24°C). Monitor the plate for mycelium growth, which can take anywhere from several days to a few weeks. Once the agar plate is fully colonized with mycelium, you can store it in the refrigerator for several months.
Agar plates are petri dishes filled with nutrient-dense agar, providing an ideal, gelatinous substance for growing mycelium. They enable mycologists to select specific strains and grow healthy, uncontaminated mycelium. Agar plates are also essential for cloning and contamination testing.
Look for the stronger genotypes and inoculate with a "single strain" or "pure strain". Rhizomorph Mycelium has a larger potency to grow into nice, healthy mushrooms than Tomentose Mycelium. Fruiting a petri dish and allowing spontaneous fruiting is another way to select the best-fruiting strain.

























